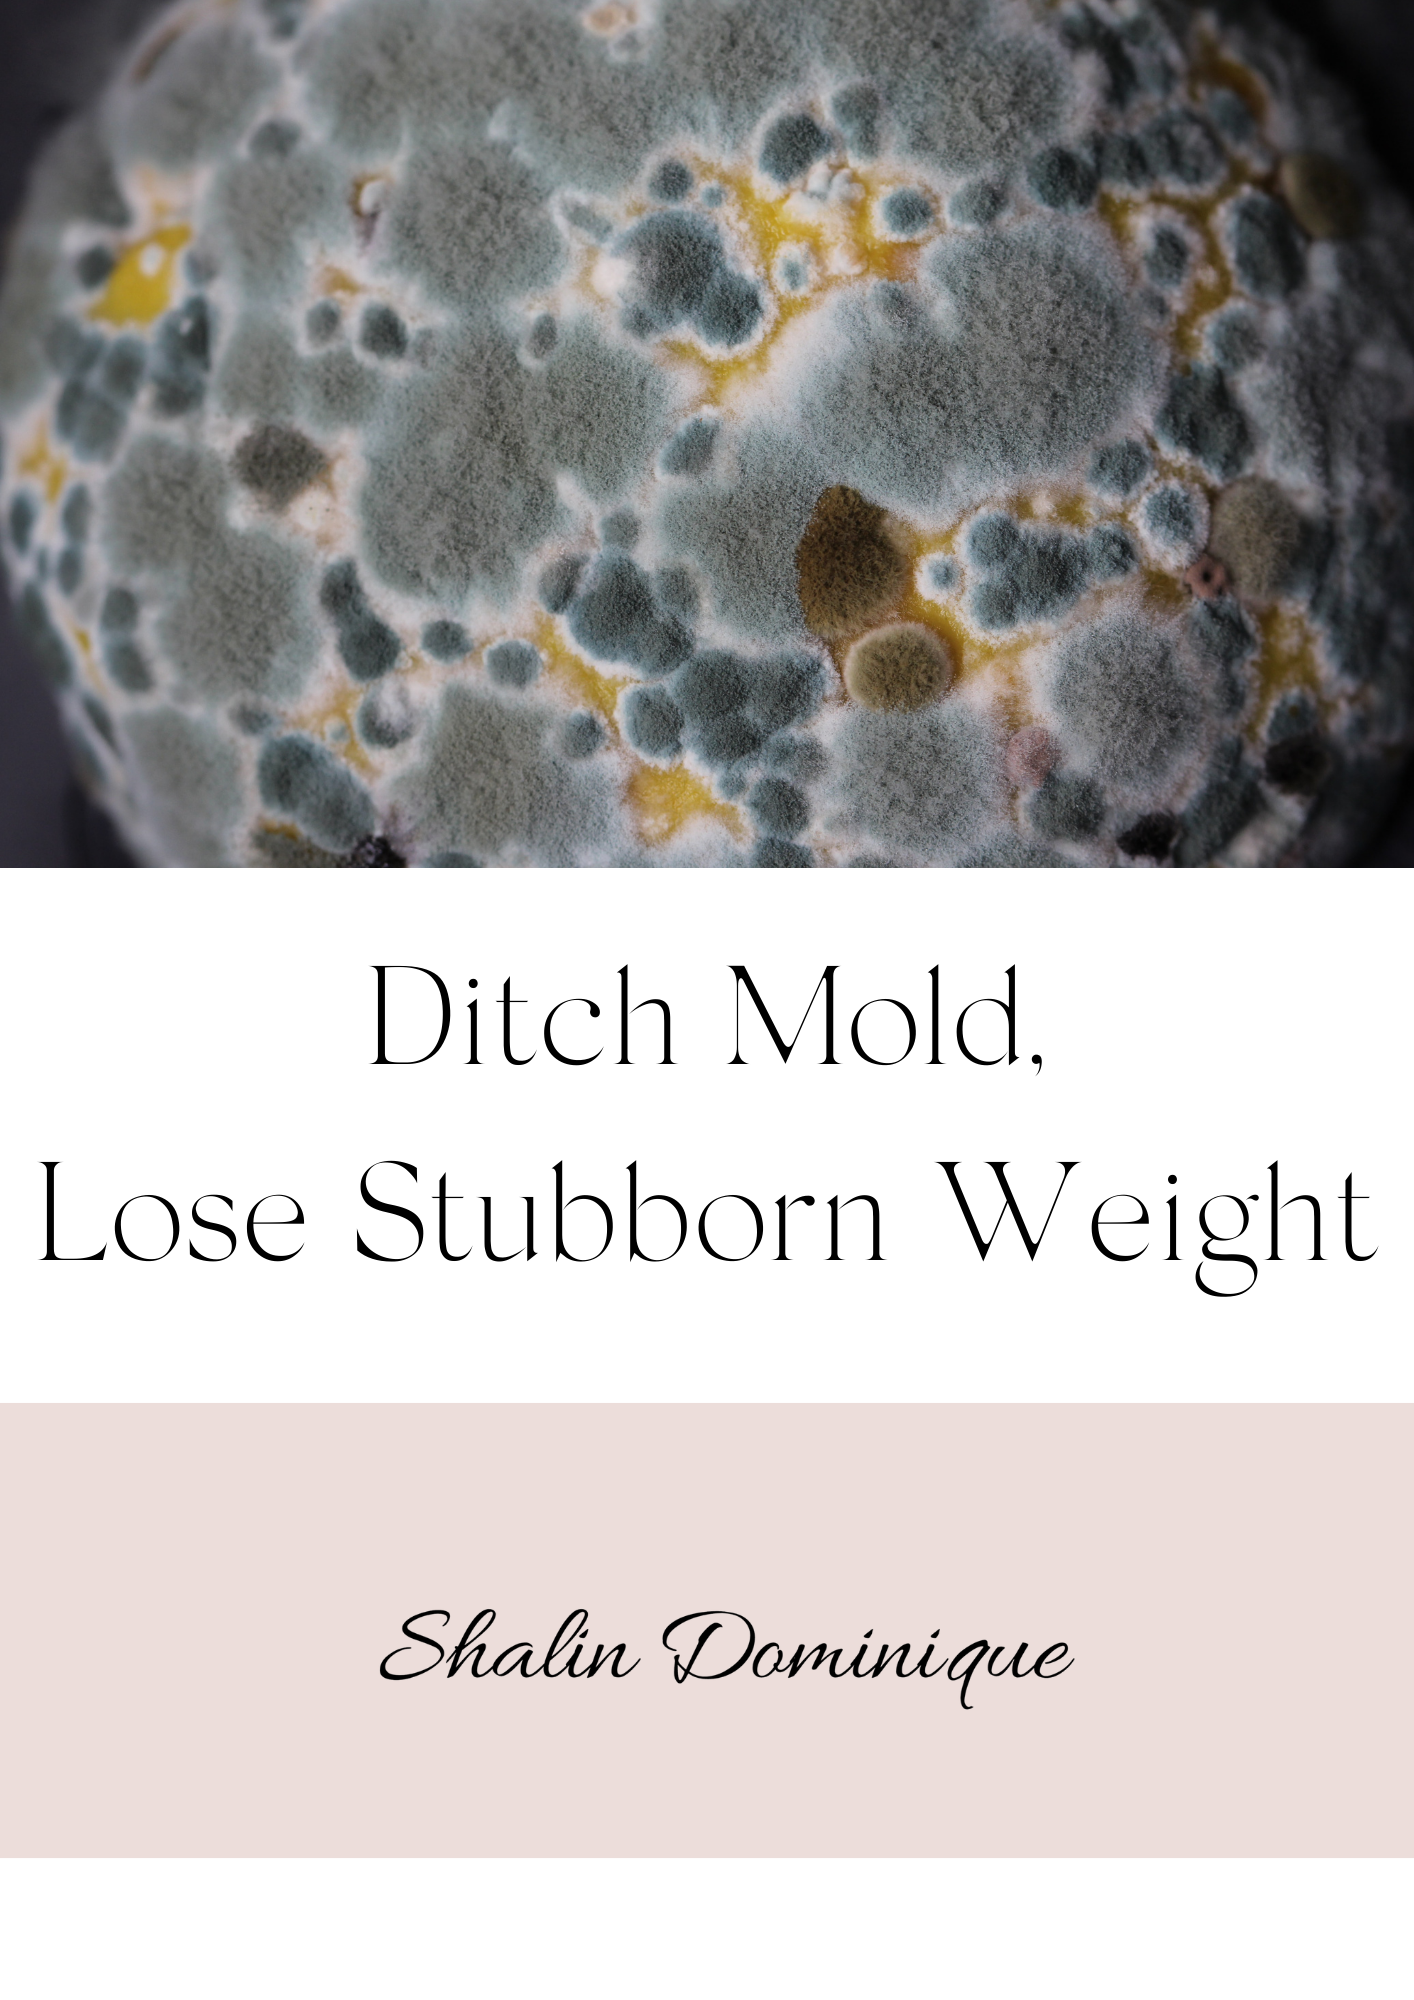
Mold - The Hidden Toxin Keeping You Inflamed, Exhausted & Weight-Loss Resistant

Mold Illness Behind Unexplainable Weight Gain
Have you been exposed to mold and your health has never been the same since? Chances are, that the mold is still in your body system causing all your symptoms, including weight gain and weight loss resistance! Let’s take a deep dive into mold illness!
Mold is a type of multicellular fungus that forms thread-like structures called Hyphae that can grow on food and surfaces with excess moisture. If you think, you’re surely not affected by mold, think twice. According to the Implementing Health Features and Practices in Buildings, 43% of buildings they examined had current water damage and 85% had past water damage. When water damage occurs, mold can grow in as little as 24-48 hours. Although molds prefer warm and moist environments, some will also grow in cooler temperatures (like in the refrigerator or cellar).
Mold illness can be a severe illness, that is often misdiagnosed as the symptoms are multifaceted and can persist even after being for months or years out of the moldy environment. One reason why it often goes undetected is, because many people assume it’s simply enough to move out of the moldy environment. While this may be true for some people, it is not true for everyone. Approximately 25% of the population have a genetic susceptibility called HLA-DR (you can get that checked in bloodwork), where the body does not properly dump spores, even AFTER leaving the moldy environment. The response of those antigens staying in the body is, that the immune system attacks the body chronically, leading to a weakened immune system, as well as to a myriad of symptoms that often seem to be far removed from the causal factor. In holistic functional medicine, understanding this genetic predisposition is crucial for creating a personalized approach to detoxification and healing.
Mold spores enter the body through inhalation and then activate an inflammatory storm in the body that severely weakens the immunity, which in turn opens the door for other infections and illnesses to manifest (parasites, Candida, Lyme +co-infections), which a healthy immune system would normally be able to keep at bay. Mold goes straight into the liver and highly reduces the livers ability to detox in phase 1, as well as the liver's ability to make energy. Further, it down regulates ATP production in the mitochondria (our cellular energy), leading to chronic fatigue. Mold exposure is the root cause of many chronic illnesses and autoimmunity cases.
Mold and weight gain + weight loss resistance
Recent published studies, mostly by Dr Shoemaker, explain the connection between mold and weight gain and/ or an inability to lose weight. The cytokine storm from mold exposure leads in many individuals - especially in the ones with the HLA-DR gene - to damaged leptin receptors in the brain. Leptin, the so-called “obesity or satiety” hormone is produced in our fat cells and is supposed to inhibit hunger and regulate energy balance. When the leptin receptors function properly, the body does not trigger hunger responses when there is no need for energy. But when these leptin receptors are damaged by a high cytokine storm from mold exposure, our fat cells attempt to compensate by producing more leptin which leads to weight gain that is in-responsive to diet or exercise
These are the most common signs and symptoms of mold illness:
Weight gain
Inability to lose weight
Depression
Anxiety ( when our body is exposed to mold and mold spores, it tells you to breathe more shallowly in order to prevent inhaling the mold spores . Shallow breathing triggers anxiety.)
Cough
Chronic fatigue, weakness
Brain fog
Cellulite
Feeling dehydrated
Rashes
Vision issues
Memory problems, difficulties with concentration
Difficulty holding urine
Headaches / head pressure
Vertigo, lightheadedness
Muscle/joint pain, cramping
Hypersensitivity to bright light
Difficulty sleeping due to disrupted melatonin
Gut inflammation which leads to constipation and bloating
Is linked to autoimmune conditions like autism, Alzheimer's, Hashimoto’s, Grave’s Disease, multiple chemical sensitivity, mast cell activation symptom, Fibromyalgia, Lupus
My Mold Story
When I was exposed to mold, I falsely believed it would be fine to just “eradicate” the mold with bleach. But I was wrong. Bleach does not kill mold on porous surfaces (like wood, carpet, soft goods, drywall, etc.), as its deep roots are underneath. It literally only removes the color on the surface, while the water component of the bleach reaches further, which can actually feed and multiply the mold growth. An alternative for effectively killing small amounts of mold is white distilled vinegar, which can kill over 80 percent of mold species commonly found in your home. As a mild acid, it can help prevent mold as well as remove it.
Within days of the exposure, I recognized a slow, but noticeable decline in my brain function: my memory got worse, simple words did not come easily to me anymore and despite keeping the same diet and exercise routine, the weight went consistently up. At first, I accepted these new symptoms as normal, until they progressed to a level where I was barely able to function and gained so much weight, that I didn’t recognize myself in the mirror anymore. I found out later, that the mold exposure weakened my immune system, and allowed parasites to take over. A common story.
Although I had left the moldy environment, the mold was still in my body (the body stores toxins / mold in fat cells, when it is not able to properly eliminate it at the time of exposure). Mold mycotoxins are highly lipophilic, that means they love to accumulate in fat (especially in the body's cellulite stores). Therefore it is essential to use a binder that does not only stay in the gut (like charcoal or bentonite clay), instead it must cross the blood-brain barrier (the brain is made mostly of fat) and be able to go into the fat to pull the mold out. Similar to parasites, mold forms and hides in a sticky biofilm, which makes it difficult to detox from it, if there is no proper protocol in place.
Common sources of mold exposure
Water damaged buildings
Leaks at homes
Cavitations, most often located in the wisdom tooth area
Breast implants
A/C units / heating units
Dishwashers
Front loading washing machines
Bathtubs / showers
Certain foods (peanuts, corn, certain berries, coffee, chocolate)
Mold and mycotoxins
Mycotoxins are naturally occurring toxins produced by certain molds and can be found in food. Those mycotoxins can be absorbed from the skin, airways and intestinal lining and affect multiple organs, like the lungs, musculoskeletal system, as well as the nervous system. Aflatoxins are amongst the most poisonous mycotoxins and are linked to cancer.
Foods high in aflatoxins
Peanuts
Corn
Milk and cheese
Nuts (especially almonds, Brazil nuts, pecans, pistachios and walnuts)
Grains including quinoa
Dried or overripe fruit
Jams and jellies
What To Do When Exposed To Mold
Get out of the environment .This is a non-negotiable. I know, it can be hard, but what’s more important in life than your health? If you are unsure whether or not your home is affected by mold, use the ERMI test from Envirobiomix or the EMMA test by Real Time Labs (gold standard) to find out.
If it’s impossible to leave your home ensure airflow by opening windows, use an air purifier and dehumidifier, plus keep the home dusted and vacuumed.
Get professional help (e.g. Moldfinders) to properly get rid of the mold.
A mycotoxin profile urine test or an OAT test can give insight into your body’s current mold toxin burden.
Open drainage pathways prior to any detox protocol (focus on the bowels, sweating, and the liver) and support mitochondria
Use binders that pull the mold out of the body. My favorite ones are Cellcore’s Biotoxin Binder, as well as Carboxy (keep in mind that Carboxy is 5x stronger than Biotoxin Binder and should only be added after tolerating Biotoxin Binder)
Use nebulizers or nasal rinses to eliminate mold in the nose. Keep in mind that mold tends to travel up, that's why you can feel more congested with those issues while being on a drainage/detox/eradication protocol.
Avoid foods that may contain mold, avoid high mercury fish, and avoid food high in oxalates or histamine.
Break free from mold toxicity and reclaim your vitality! Download now to discover how to rid your body of mold toxins and achieve your weight loss goals. It's time to thrive and shed those stubborn pounds!
This guide that reveals the hidden toxin sabotaging your metabolism, inflaming your body, and forcing your fat cells to hold on — even when you're doing everything right.
Inside: The specific binders, supplements, and the exact sequence your body needs to start releasing mold — and finally, the weight.
Inside the PDF:
✔️ Why your body is physically holding onto fat — the mycotoxin-to-fat-cell mechanism that makes weight loss impossible, no matter how little you eat
✔️ The exact 8-step clinical detox sequence — which binders to use, when to use them, and why wrong order makes you worse (+ direct links to each supplement with practitioner access)
✔️ The leptin damage loop no one explains — how mold hijacks your hunger hormones and makes your weight unresponsive to diet or exercise
✔️ The exact detox strategies most practitioners don't know to look for.
✔️ The 3 mycotoxins most likely behind your symptoms — including the one linked to extreme weight gain on low-calorie diets (it lives in ordinary household dust)
✔️ Why leaving the mold wasn't enough — the genetic factor affecting 25% of people that keeps toxins circulating for months or years after exposure
After purchase you'll receive an email with a direct download link to your PDF. The link expires within 24 hours.
~NO REFUNDS AVAILABLE - ALL SALES ARE FINAL~
Prices are in USD - please click on the document for a detailed description.